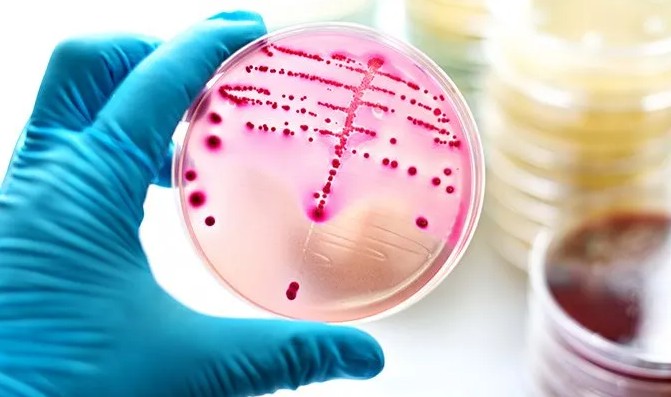
Uromed

Στρεπτόκοκκος: Συμπτώματα, Μετάδοση και Αντιμετώπιση
Ο στρεπτόκοκκος της ομάδας Α (Group A Streptococcus ή GAS) είναι ένα είδος βακτηρίου που ευθύνεται για ένα ευρύ φάσμα λοιμώξεων, από ήπιες ενοχλήσεις του δέρματος και του λαιμού, μέχρι σοβαρές και απειλητικές για τη ζωή καταστάσεις.
Η έγκαιρη αναγνώριση των συμπτωμάτων και η σωστή θεραπεία είναι καθοριστικής σημασίας για την αποφυγή επιπλοκών.
Τι είναι ο στρεπτόκοκκος της ομάδας Α
Ο στρεπτόκοκκος της ομάδας Α είναι ένα βακτήριο που προκαλεί λοιμώξεις όταν εισέρχεται στο σώμα μέσω του δέρματος ή των βλεννογόνων, όπως ο λαιμός. Υπάρχουν πάνω από 120 διαφορετικά στελέχη αυτού του βακτηρίου, καθιστώντας τον έναν από τους πιο διαδεδομένους παθογόνους μικροοργανισμούς.
Συνήθως προκαλεί ήπιες λοιμώξεις, όπως φαρυγγίτιδα, δερματικές φλεγμονές ή αμυγδαλίτιδα. Σε ορισμένες περιπτώσεις, όμως, μπορεί να οδηγήσει σε πιο σοβαρές παθήσεις όπως η σηψαιμία, ο ρευματικός πυρετός ή ακόμα και η νεκρωτική απονευρωσίτιδα.
Ποια είναι τα συχνότερα είδη λοιμώξεων από στρεπτόκοκκο
Οι λοιμώξεις που προκαλεί ο στρεπτόκοκκος της ομάδας Α διακρίνονται σε δύο βασικές κατηγορίες: ήπιες και σοβαρές.
1. Ήπιες λοιμώξεις
- Φαρυγγίτιδα / Πονόλαιμος: Ξαφνικός πόνος στον λαιμό, δυσκολία στην κατάποση, πυρετός.
- Αμυγδαλίτιδα: Οίδημα και ερυθρότητα στις αμυγδαλές, συχνά με παρουσία πύου.
- Οστρακιά: Πυρετός και εξάνθημα.
- Ερυσίπελας και κυτταρίτιδα:Φλεγμονή στο δέρμα, οίδημα, πόνος και κοκκίνισμα.
- Μολυσματικό κηρίο: Μικρές φουσκάλες ή πληγές γύρω από τη μύτη, το στόμα και τα άκρα, που σχηματίζουν κίτρινες κρούστες.
2. Σοβαρές λοιμώξεις
- Σηψαιμία: Το βακτήριο εισέρχεται στο αίμα και προκαλεί γενικευμένη λοίμωξη.
- Σύνδρομο στρεπτοκοκκικού τοξικού σοκ: Πολυοργανική ανεπάρκεια, πυρετός και εξάνθημα.
- Ρευματικός πυρετός: Φλεγμονή των αρθρώσεων και πιθανή βλάβη στις καρδιακές βαλβίδες.
- Μεταστρεπτοκοκκική σπειραματονεφρίτιδα:Επιπλοκή στους νεφρούς.
- Νεκρωτική απονευρωσίτιδα: Μια σπάνια αλλά εξαιρετικά επικίνδυνη μόλυνση των μυών και των ιστών.
Ποια είναι τα βασικά συμπτώματα της λοίμωξης από στρεπτόκοκκο
Τα συμπτώματα ποικίλουν ανάλογα με τον τύπο και τη σοβαρότητα της λοίμωξης:
Γενικά συμπτώματα:
- Πόνος ή δυσκολία στην κατάποση
- Πυρετός και ρίγη
- Πονοκέφαλος
- Ναυτία ή εμετός
- Πόνος στην κοιλιά (συχνός στα παιδιά)
- Διογκωμένοι λεμφαδένες στον λαιμό
- Ερυθρότητα και πόνος στον λαιμό ή στις αμυγδαλές
Συμπτώματα δερματικής λοίμωξης:
- Εξάνθημα στο λαιμό, τις μασχάλες ή τη βουβωνική περιοχή
- Μικρές πληγές ή φουσκάλες με κιτρινωπό υγρό
- Φαγούρα και ερυθρότητα
- Πρησμένο και θερμό δέρμα
Σοβαρά συμπτώματα:
- Έντονος πόνος που δεν ανταποκρίνεται σε παυσίπονα
- Διάρροια και εμετοί
- Ζάλη ή λιποθυμικές τάσεις
- Μαυρισμένες περιοχές δέρματος
- Δυσκολία στην αναπνοή
Πώς μεταδίδεται ο στρεπτόκοκκος
Ο στρεπτόκοκκος είναι πολύ μεταδοτικός και μεταδίδεται μέσω:
- Σταγονιδίων από βήχα ή φτέρνισμα
- Άμεσης επαφής με πληγές ή εξανθήματα
- Χρήσης κοινών αντικειμένων (ποτήρια, μαχαιροπήρουνα)
- Επαφής με μολυσμένες επιφάνειες και κατόπιν αγγίγματος της μύτης ή του στόματος
Η μεταδοτικότητα είναι υψηλότερη όταν υπάρχουν εμφανή συμπτώματα.
Διάγνωση και εξετάσεις
Η διάγνωση βασίζεται σε:
- Κλινική εξέταση και αξιολόγηση συμπτωμάτων
- Καλλιέργεια φαρυγγικού επιχρίσματος ή γρήγορο τεστ στρεπτόκοκκου
- Εξετάσεις αίματος
- Απεικονιστικός έλεγχος (σε περιπτώσεις δερματικών λοιμώξεων ή αποστημάτων)
Ποια είναι η θεραπεία για τις στρεπτοκοκκικές λοιμώξεις
Η βασική γραμμή θεραπείας είναι τα αντιβιοτικά.
Τα πιο συχνά χρησιμοποιούμενα είναι:
- Πενικιλλίνη
- Αμοξικιλλίνη
Εναλλακτικές επιλογές για άτομα με αλλεργία:
- Κεφαλεξίνη
- Αζιθρομυκίνη
- Κλινδαμυκίνη
Για δερματικές λοιμώξεις, μπορεί να δοθούν τοπικές αντιβιοτικές αλοιφές (π.χ. μουπιροσίνη).
Τα αντιβιοτικά:
- Μειώνουν τη διάρκεια της ασθένειας
- Περιορίζουν τα συμπτώματα
- Εμποδίζουν την εξάπλωση της μόλυνσης
- Προλαμβάνουν σοβαρές επιπλοκές
Πότε πρέπει να επισκεφτείτε γιατρό
Αναζητήστε ιατρική βοήθεια εάν:
- Τα συμπτώματα επιμένουν πάνω από 5-7 ημέρες
- Έχετε υψηλό πυρετό που δεν υποχωρεί
- Παρατηρήσετε εξάνθημα, πληγές ή πρήξιμο στο δέρμα
- Υπάρχουν ενδείξεις σοβαρής λοίμωξης (έντονος πόνος, μαυρίσματα στο δέρμα, δυσκολία στην αναπνοή)
Υπάρχει πρόληψη για τον στρεπτόκοκκο
Αν και δεν υπάρχει ακόμη διαθέσιμο εμβόλιο, μπορείτε να μειώσετε τον κίνδυνο μόλυνσης με απλά μέτρα:
- Συχνό πλύσιμο των χεριών με σαπούνι και νερό
- Αποφυγή κοινής χρήσης ποτηριών και σκευών
- Κάλυψη στόματος και μύτης κατά το φτέρνισμα ή τον βήχα
- Καθαρισμός και κάλυψη πληγών
- Παραμονή στο σπίτι όταν είστε άρρωστοι.
Συμπέρασμα
Οι λοιμώξεις από στρεπτόκοκκο της ομάδας Α είναι συχνές και στις περισσότερες περιπτώσεις αντιμετωπίζονται αποτελεσματικά με αντιβιοτικά.
Ωστόσο, η έγκαιρη διάγνωση και θεραπεία είναι κρίσιμες για την αποφυγή σοβαρών επιπλοκών. Αν παρουσιάσετε ύποπτα συμπτώματα, απευθυνθείτε άμεσα στον γιατρό σας.